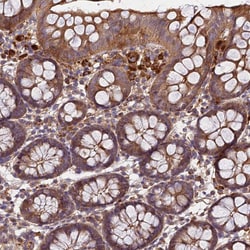
Invitrogen C17orf62 Polyclonal Antibody 100 &mu;L; Unconjugated:Anticuerpos

missing translation for 'onlineSavingsMsg'
Learn More
Learn More
Descripción
Immunogen sequence: MVVLRLATGF SHPLTQSAVM GHRSDVEAIA KLITSFLELH CLESPTELSQ SSDSEAGDPA SQS Highest antigen sequence identity to the following orthologs: Mouse - 84%, Rat - 84%.
C17orf62 is a protein coding gene.

Especificaciones
Especificaciones
| Antígeno | C17orf62 |
| Aplicaciones | Immunohistochemistry (Paraffin), Immunocytochemistry |
| Clasificación | Polyclonal |
| Concentración | 0.5 mg/mL |
| Conjugado | Unconjugated |
| Formulación | PBS with 40% glycerol and 0.02% sodium azide; pH 7.2 |
| génica | C17ORF62 |
| N.º de referencia del gen | Q9BQA9 |
| Alias de gen | C17orf62; chromosome 17 open reading frame 62; CYBC1; Cytochrome b-245 chaperone 1; EROS; Essential for reactive oxygen species protein; HAPSTR1; uncharacterized protein C17orf62 |
| Símbolos de los genes | C17ORF62 |
| Mostrar más |
Título del producto
Al hacer clic en Enviar, acepta que Fisher Scientific se ponga en contacto con usted en relación con los comentarios que ha proporcionado en este formulario. No compartiremos su información para ningún otro fin. Toda la información de contacto proporcionada se mantendrá de acuerdo con nuestra Política de Privacidad. Política de privacidad.
¿Detecta una oportunidad de mejora?